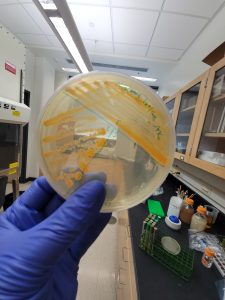

Research in the Microbiology 304 Instructional Lab Course
Even in the introductory Micro304 Laboratory Course undergraduates have the opportunity to engage in authentic scientific discovery. Replacing conventional lab courses with discovery-based research has strong benefits not only for student’s engagement in class, but in their interest in science and immense benefits for their future career. Students develop a sense of project ownership and have a ready-made personal research project at a fraction of the cost of traditional apprentice-based research programs.
After learning the basic techniques in the first few weeks, the laboratory activities are designed ask open-ended questions, allow for students to “choose their own direction”, and/or investigate a biological question that has never before been investigated. Keep reading for a sampling of the types of research that undergraduates perform and their results.
Test effectiveness of antibiotics
Humans use many means to control the growth of microbes where they are not wanted, chemicals called antibiotics have been used for ~100 years and have revolutionized modern medicine. Even on a daily basis we use hand-sanitizer or bleach to prevent microbial growth. In lab students can test an antimicrobial compound of their choosing. Students develop a hypothesis regarding an antimicrobial, then implement the scientific method to design and then carry out an experiment to test their chosen compound. Through this activity, students ask and answer a scientific question of their choosing, many times this is a question that has never before been asked.
In this example, a pre-dental student was interested in the effectiveness of ACT© Anticavity Mouthwash, so designed and implemented a minimum inhibitory concentration test. Her data shows growth was inhibited even at the smallest concentration tested, which happens to be much less than the recommended dose.

Identify and characterize novel bacteria from nature samples
After learning the basic techniques used in a microbiology lab, students isolate, identify, and characterize a novel bacterial species from nature sample of their choosing. In this individual project that spans the semester students build and solidify their use of common lab techniques in an authentic, valuable, yet accessible research project. Every semester at least one student identifies a novel species that has never before been characterized or studied!
This student was interested in the microbiome of freshwater mussels. They isolated and identified a novel bacterium from the Microbacteriaceae family, closely related to Microbacterium species.
Isolate novel bacteriophages
The investigation and isolation of novel bacteriophages is drastically understudied, yet in the instructional lab holds immense promise for not only in students learning laboratory techniques to work with bacteriophages, but could serve as potential future antimicrobial therapies to treat antibiotic-resistant bacterial infections. Students assist the professor in the isolation of novel bacteriophages from nature samples, then characterize them using classic host typing and plaque assays.
In this example, a student isolated a novel bacteriophage that infects the Acinetobacter baylyi bacterium.
For more information…blah blah needs updated


